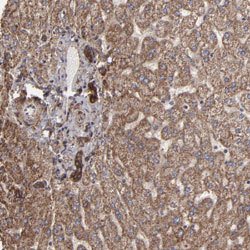
ITGB5 Rabbit anti-Human, Polyclonal, Abnova 100uL:Antibodies, Polyclonal

missing translation for 'onlineSavingsMsg'
Learn More
Learn More
ITGB5 Rabbit anti-Human, Polyclonal, Abnova™
Rabbit Polyclonal Antibody
Brand: Abnova PAB30319.100uL
This item is not returnable.
View return policy
Description
Rabbit polyclonal antibody raised against partial recombinant human ITGB5.
- High specificity
- High reactivity
Specifications
| ITGB5 | |
| Polyclonal | |
| Rabbit polyclonal antibody raised against partial recombinant human ITGB5. | |
| In PBS, pH 7.2 (40% glycerol, 0.02% sodium azide). | |
| FLJ26658 | |
| Rabbit | |
| Antigen affinity purification | |
| RUO | |
| 3693 | |
| Store at 4°C. For long term storage store at -20°C. Aliquot to avoid repeated freezing and thawing. |
|
| IgG |
| Immunohistochemistry (PFA fixed) | |
| Unconjugated | |
| Immunohistochemistry (Formalin/PFA-fixed paraffin-embedded sections) (1:50-1:200) The optimal working dilution should be determined by the end user. | |
| P18084 | |
| ITGB5 | |
| Recombinant protein corresponding to human ITGB5. | |
| 100 μL | |
| Primary | |
| Human | |
| Liquid |
Product Content Correction
Your input is important to us. Please complete this form to provide feedback related to the content on this product.
Product Title
For Research Use Only (RUO)
Spot an opportunity for improvement?Share a Content Correction